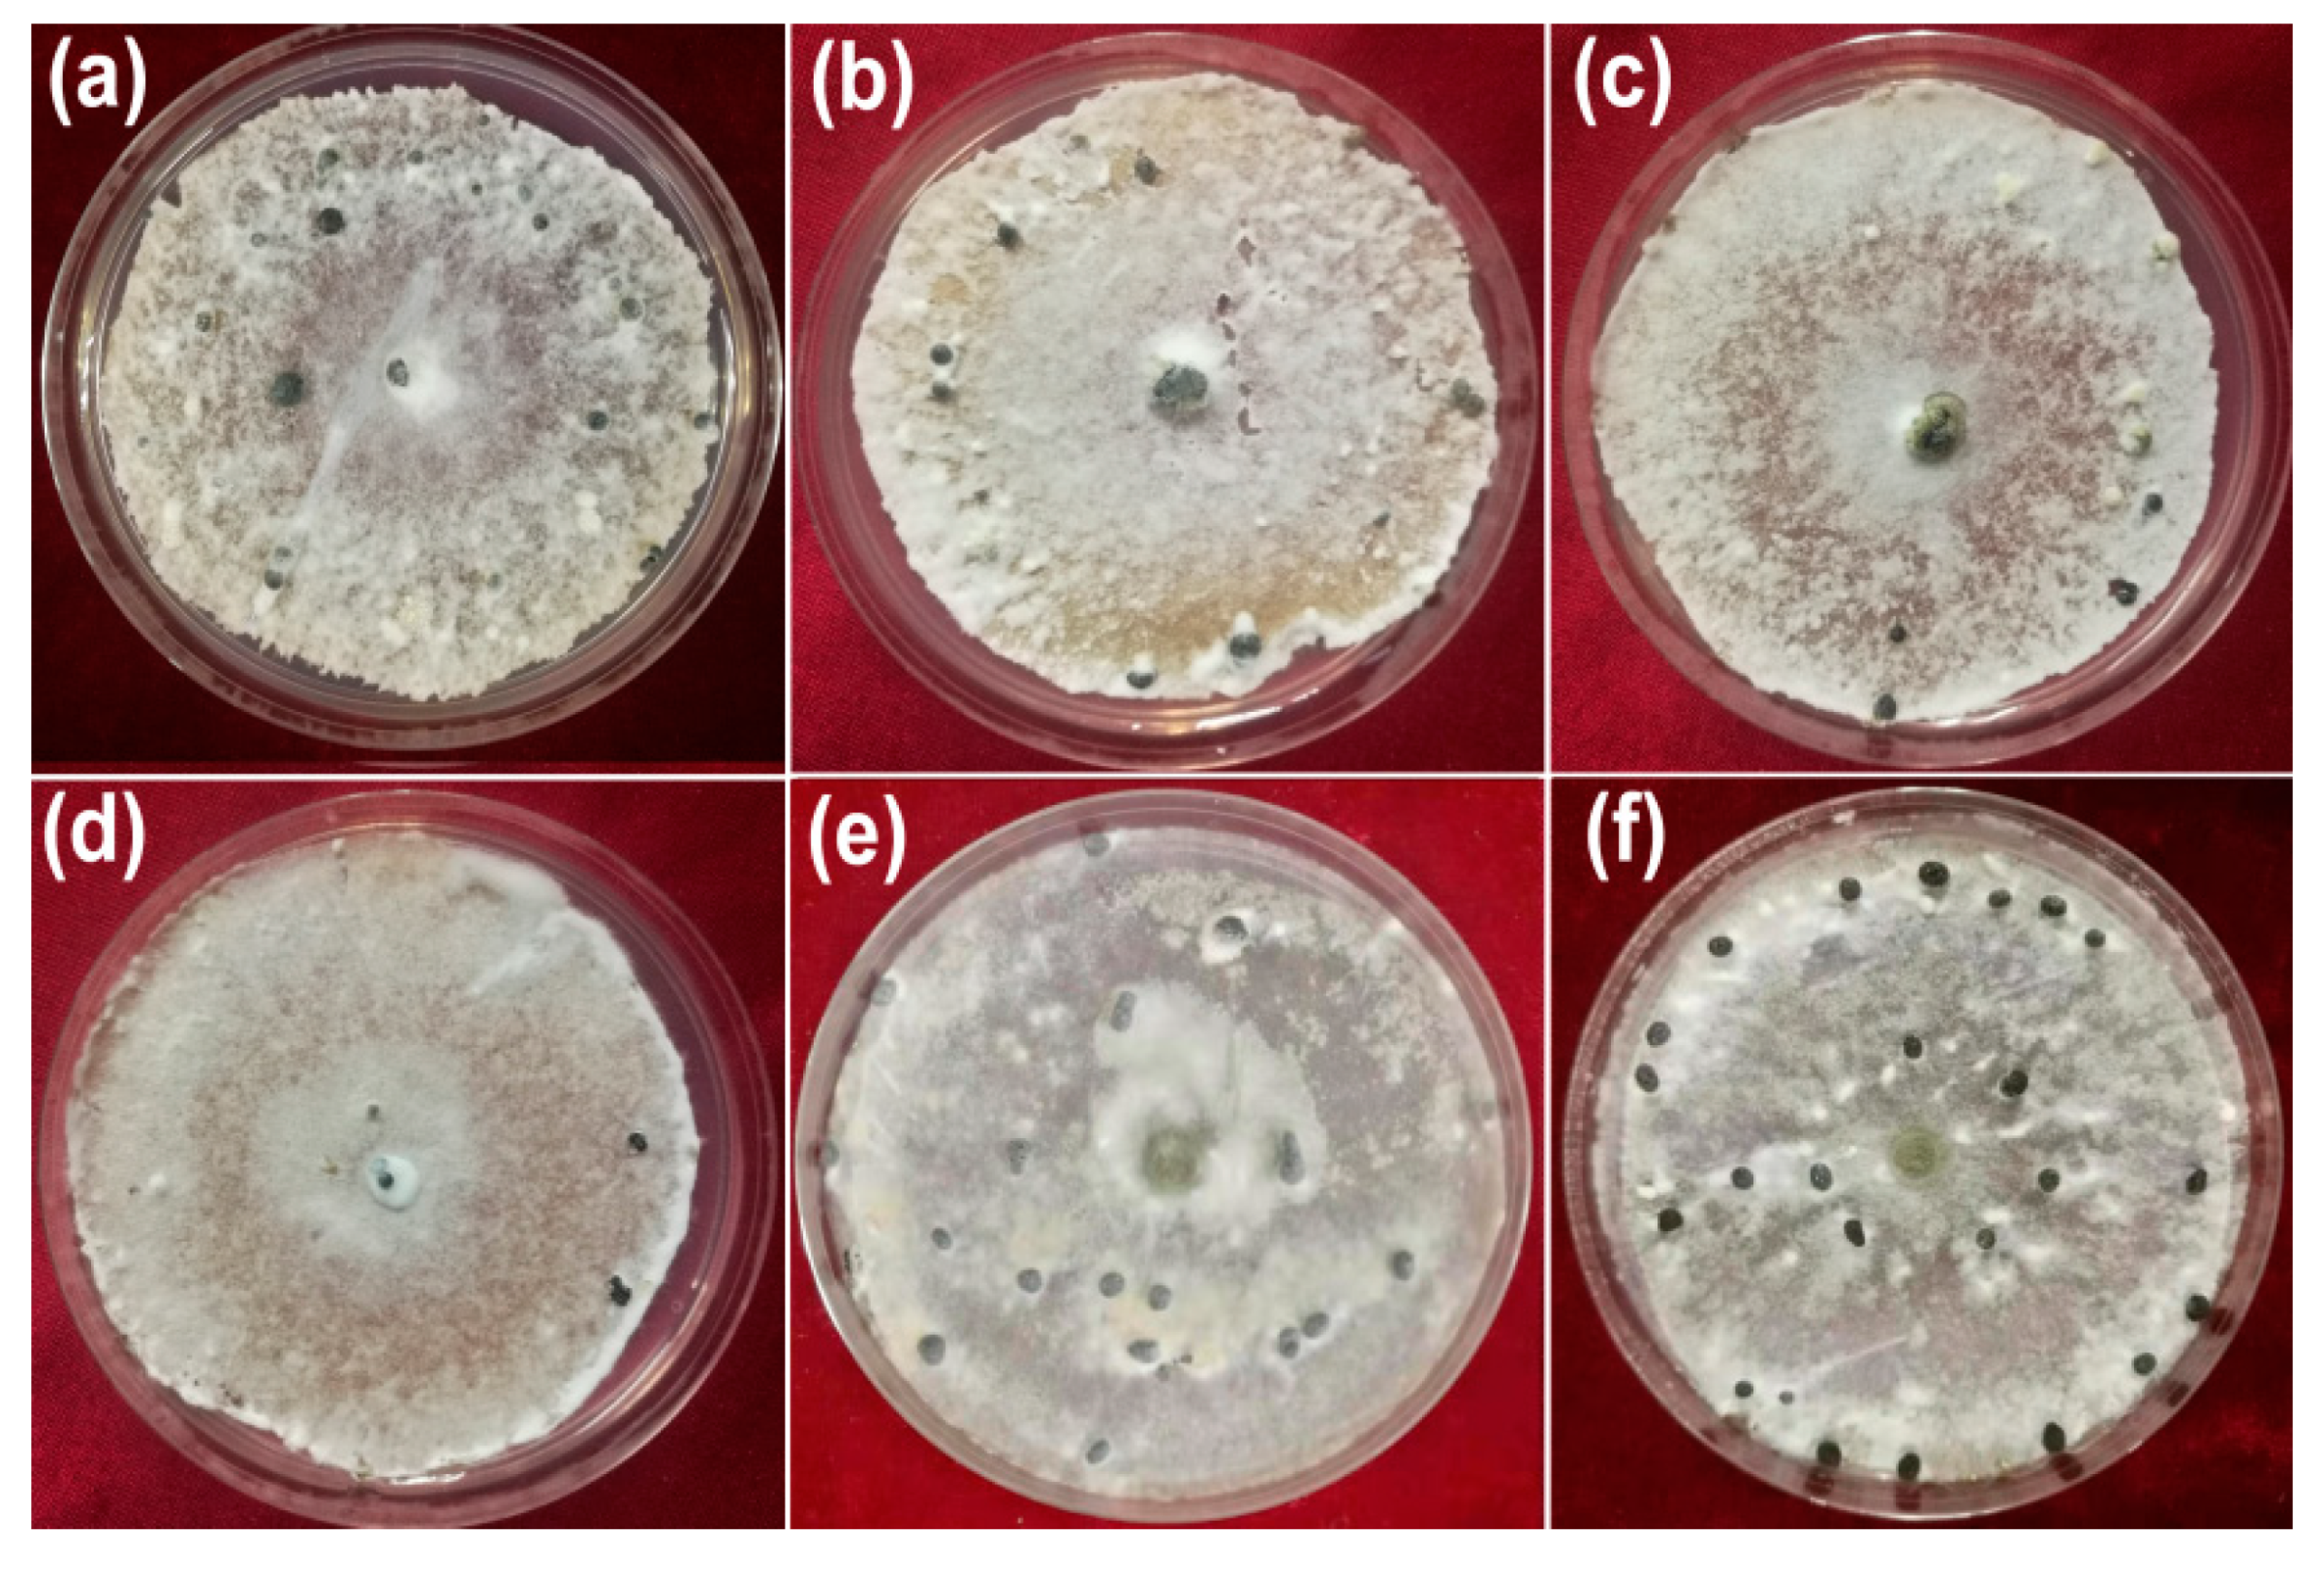
Nanomaterials 10 01955 g005

Mycosynthesis of Silver Nanoparticles Using Screened Trichoderma Isolates and Their Antifungal Activity against Sclerotinia sclerotiorum
Abstract
:1. Introduction
2. Materials and Methods
2.1. Fungal Isolates and Mycelial Growth
2.2. Synthesis of Silver Nanoparticles Using Trichoderma Isolates.
2.3. Characterization of AgNPs
2.4. Inhibitory Activity of Synthetic AgNPs against Mycelial Growth
2.5. Effect of AgNPs on Sclerotial Production
2.6. Determination of Effect of AgNPs on, Myceliogenic Germination of Sclerotia
3. Results
3.1. Synthesis of Nanoparticles
3.2. Characterization of AgNPs
3.3. Inhibitory Activity against Hyphal Growth
3.4. Inhibitory Activity against Sclerotial Production
3.5. Inhibitory Activity against Myceliogenic Germination of Sclerotia
4. Discussion
5. Conclusions
Author Contributions
Funding
Acknowledgments
Conflicts of Interest
References
- Purdy, L.H. Sclerotinia sclerotiorum: History, diseases and symptomatology, host range, geographic distribution, and impact. Phytopathology 1979, 69, 875–880. [Google Scholar] [CrossRef]
- Boland, G.J.; Hall, R. Index of plant hosts of Sclerotinia sclerotiorum. Can. J. Plant Pathol. 1994, 16, 93–108. [Google Scholar] [CrossRef]
- Coley-Smith, J.R.; Cooke, R.C. Survival and germination of fungal sclerotia. Annu. Rev. Phytopathol. 1971, 9, 65–92. [Google Scholar] [CrossRef]
- Bolton, M.D.; Thomma, B.P.; Nelson, B.D. Sclerotinia sclerotiorum (Lib.) de Bary: Biology and molecular traits of a cosmopolitan pathogen. Mol. Plant Pathol. 2006, 7, 1–16. [Google Scholar]
- Wang, Z.; Ma, L.Y.; Cao, J.; Li, Y.L.; Ding, L.N.; Zhu, K.M.; Yang, Y.H.; Tan, X.L. Recent advances in mechanisms of plant defense to Sclerotinia sclerotiorum. Front. Plant Sci. 2019, 10, 1314. [Google Scholar] [CrossRef]
- Xilin, Z.; Xuemei, S.; Gufeng, Z. Preliminary Report on the Monitoring of the Resistance of Sclerotinia Libertiana to Carbendazim and its Integrated Management. Pestic. Sci. Adm. 2003, 6, 18–22. [Google Scholar]
- Rai, M.; Yadav, A.; Gade, A. Silver nanoparticles as a new generation of antimicrobials. Biotechnol. Adv. 2009, 27, 76–83. [Google Scholar] [CrossRef]
- Rudakiya, D.M.; Pawar, K. Bactericidal potential of silver nanoparticles synthesized using cell-free extract of Comamonas acidovorans: In vitro and in silico approaches. 3 Biotech 2017, 7, 1–12. [Google Scholar] [CrossRef] [Green Version]
- Prabhu, S.; Poulose, E.K. Silver nanoparticles: Mechanism of antimicrobial action, synthesis, medical applications, and toxicity effects. Int. Nano Lett. 2012, 2, 32. [Google Scholar] [CrossRef] [Green Version]
- Rai, M.; Kon, K.; Ingle, A.; Duran, N.; Galdiero, S.; Galdiero, M. Broad-spectrum bioactivities of silver nanoparticles: The emerging trends and future prospects. Appl. Microbiol. Biotechnol. 2014, 98, 1951–1961. [Google Scholar] [CrossRef]
- Gupta, R.K.; Kumar, V.; Gundampati, R.K.; Malviya, M.; Hasan, S.H.; Jagannadham, M.V. Biosynthesis of silver nanoparticles from the novel strain of Streptomyces sp. BHUMBU-80 with highly efficient electroanalytical detection of hydrogen peroxide and antibacterial activity. J. Environ. Chem. Eng. 2017, 5, 5624–5635. [Google Scholar]
- Loo, Y.Y.; Rukayadi, Y.; Nor-Khaizura, M.A.; Kuan, C.H.; Chieng, B.W.; Nishibuchi, M.; Radu, S. In vitro antimicrobial activity of green synthesized silver nanoparticles against selected gram-negative foodborne pathogens. Front. Microbiol. 2018, 9, 1555. [Google Scholar] [CrossRef]
- Guilger-Casagrande, M.; de Lima, R. Synthesis of silver nanoparticles mediated by fungi: A Review. Front. Bioeng. Biotechnol. 2019, 7, 287. [Google Scholar] [CrossRef] [PubMed] [Green Version]
- Vahabi, K.; Dorcheh, S.K. Biosynthesis of silver nano-particles by Trichoderma and its medical applications. In Biotechnology and Biology of Trichoderma; Gupta, V., Schmoll, M., Herrera-Estrella, A., Upadhyay, R.S., Druzhinina, I., Tuohy, M., Eds.; Elsevier: London, UK, 2014; pp. 393–404. [Google Scholar]
- Mukherjee, P.; Roy, M.; Mandal, B.P.; Dey, G.; Mukherjee, P.K.; Ghatak, J.; Tyagi, A.K.; Kale, S.P. Green synthesis of highly stabilized nanocrystalline silver particles by a non-pathogenic and agriculturally important fungus T. asperellum. Nanotechnology 2008, 19, 075103. [Google Scholar] [CrossRef]
- Vahabi, K.; Mansoori, G.A.; Karimi, S. Biosynthesis of silver nanoparticles by fungus Trichoderma reesei (a route for large-scale production of AgNPs). Insciences J. 2011, 1, 65–79. [Google Scholar] [CrossRef]
- Tripathi, R.M.; Gupta, R.K.; Shrivastav, A.; Singh, M.P.; Shrivastav, B.R.; Singh, P. Trichoderma koningii assisted biogenic synthesis of silver nanoparticles and evaluation of their antibacterial activity. Adv. Nat. Sci. Nanosci. Nanotechnol. 2013, 4, 035005. [Google Scholar] [CrossRef]
- Sundaravadivelan, C.; Padmanabhan, M.N. Effect of mycosynthesized silver nanoparticles from filtrate of Trichoderma harzianum against larvae and pupa of dengue vector Aedes aegypti L. Environ. Sci. Pollut. Res. Int. 2014, 21, 4624–4633. [Google Scholar] [CrossRef]
- Othman, A.M.; Elsayed, M.A.; Elshafei, A.M.; Hassan, M.M. Application of response surface methodology to optimize the extracellular fungal mediated nanosilver green synthesis. J. Genet. Eng. Biotechnol. 2017, 15, 497–504. [Google Scholar] [CrossRef] [PubMed]
- Elamawi, R.M.; Al-Harbi, R.E.; Hendi, A.A. Biosynthesis and characterization of silver nanoparticles using Trichoderma longibrachiatum and their effect on phytopathogenic fungi. Egypt J Biol Pest Control 2018, 28, 28. [Google Scholar] [CrossRef] [Green Version]
- Lamsal, K.; Kim, S.W.; Jung, J.H.; Kim, Y.S.; Kim, K.S.; Lee, Y.S. Application of silver nanoparticles for the control of Colletotrichum species in vitro and pepper anthracnose disease in field. Mycobiology 2011, 39, 194–199. [Google Scholar] [CrossRef] [Green Version]
- Guilger, M.; Pasquoto-Stigliani, T.; Bilesky-Jose, N.; Grillo, R.; Abhilash, P.C.; Fraceto, L.F.; De Lima, R. Biogenic silver nanoparticles based on Trichoderma harzianum: Synthesis, characterization, toxicity evaluation and biological activity. Sci. Rep.-UK 2017, 7, 44421. [Google Scholar] [CrossRef]
- Tomah, A.A.; Abd Alamer, I.S.; Li, B.; Zhang, J.-Z. A new species of Trichoderma and gliotoxin role: A new observation in enhancing biocontrol potential of T. virens against Phytophthora capsici on chili pepper. Biol. Control 2020, 145, 104261. [Google Scholar]
- Bhainsa, K.C.; D’souza, S.F. Extracellular biosynthesis of silver nanoparticles using the fungus Aspergillus fumigatus. Colloids Surf. B Biointerfaces 2006, 47, 160–164. [Google Scholar] [CrossRef] [PubMed]
- Fayaz, A.M.; Balaji, K.; Girilal, M.; Yadav, R.; Kalaichelvan, P.T.; Venketesan, R. Biogenic synthesis of silver nanoparticles and their synergistic effect with antibiotics: A study against gram-positive and gram-negative bacteria. Nanomed. Nanotechnol. Biol. Med. 2010, 6, 103–109. [Google Scholar] [CrossRef] [PubMed]
- Bahrami-Teimoori, B.; Nikparast, Y.; Hojatianfar, M.; Akhlaghi, M.; Ghorbani, R.; Pourianfar, H.R. Characterisation and antifungal activity of silver nanoparticles biologically synthesised by Amaranthus retroflexus leaf extract. J. Exp. Nanosci. 2017, 12, 129–139. [Google Scholar] [CrossRef] [Green Version]
- Soylu, S.; Yigitbas, H.; Soylu, E.M.; Kurt, Ş. Antifungal effects of essential oils from oregano and fennel on Sclerotinia sclerotiorum. J. Appl. Microbiol. 2007, 103, 1021–1030. [Google Scholar] [CrossRef]
- Li, X.; Ojaghian, M.R.; Zhang, J.Z.; Zhu, S.J. A new species of Scopulariopsis and its synergistic effect on pathogenicity of Verticillium dahliae on cotton plants. Microbiol. Res. 2017, 201, 12–20. [Google Scholar] [CrossRef]
- Amargeetha, A.; Velavan, S. X-ray diffraction (XRD) and energy dispersive spectroscopy (EDS) analysis of silver nanoparticles synthesized from Erythrina indica flowers. Nanosci Technol. 2018, 5, 1–5. [Google Scholar]
- Kumar, C.G.; Mamidyala, S.K. Extracellular synthesis of silver nanoparticles using culture supernatant of Pseudomonas aeruginosa. Colloid Surface B. 2011, 84, 462–466. [Google Scholar] [CrossRef]
- Shameli, K.; Bin Ahmad, M.; Jazayeri, S.D.; Sedaghat, S.; Shabanzadeh, P.; Jahangirian, H.; Mahdavi, M.; Abdollahi, Y. Synthesis and characterization of polyethylene glycol mediated silver nanoparticles by the green method. Int. J. Mol. Sci. 2012, 13, 6639. [Google Scholar] [CrossRef] [Green Version]
- Jain, N.; Bhargava, A.; Majumdar, S.; Tarafdar, J.C.; Panwar, J. Extracellular biosynthesis and characterization of silver nanoparticles using Aspergillus flavus NJP08: A mechanism perspective. Nanoscale 2011, 3, 635–641. [Google Scholar] [CrossRef] [PubMed]
- Gupta, K.; Jana, P.C.; Meikap, A.K. Optical and electrical transport properties of polyaniline–silver nanocomposite. Synth. Met. 2010, 160, 1566–1573. [Google Scholar] [CrossRef]
- Abreu, D.S.; Sousa, T.P.; Castro, C.B.; Sousa, M.N.V.; Silva, T.T.; Almeida-Neto, F.W.Q.; Queiros, M.V.A.; Rodrigues, B.S.F.; Oliveira, M.C.F.; Paulo, T.F. SAM of Gliotoxin on Gold: A Natural Product Platform for Sugar Recognition based on the Immobilization of Canavalia brasiliensis lectin (ConBr). Electrochim. Acta 2017, 241, 116–123. [Google Scholar] [CrossRef]
- Firdhouse, M.J.; Lalitha, P. Biosynthesis of silver nanoparticles and its applications. J. Nanotechnol. 2015, 2015, 1–18. [Google Scholar] [CrossRef] [Green Version]
- Kim, S.H.; Lee, H.S.; Ryu, D.S.; Choi, S.J.; Lee, D.S. Antibacterial activity of silver-nanoparticles against Staphylococcus aureus and Escherichia coli. Korean J. Microbiol. Biotechnol. 2011, 39, 77–85. [Google Scholar]
- Dakal, T.C.; Kumar, A.; Majumdar, R.S.; Yadav, V. Mechanistic basis of antimicrobial actions of silver nanoparticles. Front. Microbiol. 2016, 7, 1831. [Google Scholar] [CrossRef] [Green Version]
- Saklani, V.; Suman, J.V.K.; Jain, K. Microbial synthesis of silver nanoparticles: A review. J. Biotechnol. Biomater. 2012, 13, 2718–2725. [Google Scholar] [CrossRef]
- Iravani, S.; Korbekandi, H.; Mirmohammadi, S.V.; Zolfaghari, B. Synthesis of silver nanoparticles: Chemical, physical and biological methods. Res. Pharm. Sci. 2014, 9, 385–406. [Google Scholar]
- Jeevan, P.; Ramya, K.; Rena, A.E. Extracellular biosynthesis of silver nanoparticles by culture supernatant of Pseudomonas aeruginosa. Ind. J. Biotechnol. 2012, 11, 72–76. [Google Scholar]
- Devi, T.P.; Kulanthaivel, S.; Kamil, D.; Borah, J.L.; Prabhakaran, N.; Srinivasa, N. Biosynthesis of silver nanoparticles from Trichoderma species. Indian J. Exp. Biol. 2013, 51, 543–547. [Google Scholar]
- Mishra, S.; Singh, H.B. Biosynthesized silver nanoparticles as a nanoweapon against phytopathogens: Exploring their scope and potential in agriculture. Appl. Microbiol. Biotechnol. 2015, 99, 1097–1107. [Google Scholar] [CrossRef] [PubMed]
- Chen, J.; Wu, L.; Lu, M.; Lu, S.; Li, Z.; Ding, W. Comparative Study on the Fungicidal Activity of Metallic MgO Nanoparticles and Macroscale MgO against Soilborne Fungal Phytopathogens. Front. Microbiol. 2020, 11, 365. [Google Scholar] [CrossRef] [PubMed] [Green Version]
- Villaverde, J.J.; Sevilla-Morán, B.; López-Goti, C.; Alonso-Prados, J.L.; Sandín-España, P. Considerations of nano-QSAR/QSPR models for nanopesticide risk assessment within the European legislative framework. Sci. Total Environ. 2018, 634, 1530–1539. [Google Scholar] [CrossRef]

| No. | Description | Wavenumber (cm−1) | Differences | Possible Reason for the Shift Alteration | |
|---|---|---|---|---|---|
| Fungal Extract | AgNPs Powder | ||||
| 1 | N–H stretching vibrations | – | 3421.24 | – | Interaction with proteins |
| 2 | O–H stretching vibrations | 3369 | 3292.99 | −76.20 | Interaction with proteins or negatively charged carboxyl groups in gliotoxin |
| 3 | C–H stretching vibration (alkanes) | 2853.06 | 2851.02 | −2.04 | Interaction with fatty acids and carbohydrates |
| 4 | CO2 stretching vibrations | – | 2360.24 and 2341.89 | – | An increase in carbon dioxide in the extract or poor purge stability of the instrument |
| 5 | Carbonyl group (C=O), amide I group stretching vibrations | 1654.56 | 1653.61 | −0.95 | Binding with proteins |
| 6 | Amide II group stretching vibrations | 1541.77 | 1540.80 | −0.97 | Interaction with proteins |
| 7 | P=O stretching in phospholipids and the C=O group in polysaccharides | 1080.44 | 1077.96 | −2.48 | Interactions with lipids and carbohydrates |
| 8 | C–H bending vibration that was adjacent to the substituent group | – | 832.17 | +13.49 1 | Interactions with heterocyclic compounds |
| 9 | C–S–H group stretching vibrations | – | 668.59 | +18.33 1 | Ag binding with sulfur from the reduced forms of gliotoxin |
| 10 | C–O–C and P–O–C on phospholipids, aromatics, amino acids and ketones stretching vibrations | 571.55 | 568.44 | −3.11 | Interactions with phospholipids, aromatics, amino acids and ketones. |
| 11 | O–Ag stretching vibrations | – | 472.49 | – | Ag binding with oxygen from hydroxyl groups of gliotoxin |
| Treatments | HG (mm) | PI (%) 1 | SP (no.) | PI% 2 | MSG (no.) | PI% 3 |
|---|---|---|---|---|---|---|
| AgNPs (50 μg/mL) | 28.31 ± 0.8 | 66.70 ± 0.9 d | 18.50 ± 0.5 | 23.70 ± 2.3 d | 1.00 ± 0.8 | 80 ± 16.0 b |
| AgNPs (100 μg/mL) | 23.78 ± 1.1 | 72.03 ± 1.3 c | 11.00 ± 0.8 | 54.63 ± 3.3 c | 0.00 ± 0.0 | 100 ± 0.0 a |
| AgNPs (150 μg/mL) | 14.66 ± 0.1 | 82.75 ± 0.1 b | 5.75 ± 0.9 | 76.33 ± 3.4 b | 0.00 ± 0.0 | 100 ± 0.0 a |
| AgNPs (200 μg/mL) | 0.0 ± 0.0 | 100 ± 0.0 a | 1.50 ± 0.5 | 93.81 ± 2.0 a | 0.00 ± 0.0 | 100 ± 0.0 a |
| Tv-CFA (50%) | 64.75 ± 0.4 | 23.82 ± 0.4 e | 19.75 ± 0.9 | 18.55 ± 3.8 e | 2.75 ± 0.5 | 45 ± 9.7 c |
| ddH2O | 85.00 ± 0.0 | - | 24.25 ± 0.9 | - | 5.00 ± 0.0 | - |
© 2020 by the authors. Licensee MDPI, Basel, Switzerland. This article is an open access article distributed under the terms and conditions of the Creative Commons Attribution (CC BY) license (http://creativecommons.org/licenses/by/4.0/).
Share and Cite
Tomah, A.A.; Alamer, I.S.A.; Li, B.; Zhang, J.-Z. Mycosynthesis of Silver Nanoparticles Using Screened Trichoderma Isolates and Their Antifungal Activity against Sclerotinia sclerotiorum. Nanomaterials 2020, 10, 1955. https://doi.org/10.3390/nano10101955
Tomah AA, Alamer ISA, Li B, Zhang J-Z. Mycosynthesis of Silver Nanoparticles Using Screened Trichoderma Isolates and Their Antifungal Activity against Sclerotinia sclerotiorum. Nanomaterials. 2020; 10(10):1955. https://doi.org/10.3390/nano10101955
Chicago/Turabian StyleTomah, Ali Athafah, Iman Sabah Abd Alamer, Bin Li, and Jing-Ze Zhang. 2020. "Mycosynthesis of Silver Nanoparticles Using Screened Trichoderma Isolates and Their Antifungal Activity against Sclerotinia sclerotiorum" Nanomaterials 10, no. 10: 1955. https://doi.org/10.3390/nano10101955







